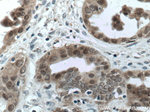
S100A11 Antibody in Immunohistochemistry (Paraffin) (IHC (P))

Search
Proteintech
S100A11 Monoclonal Antibody (1A3F1)
{{$productOrderCtrl.translations['antibody.pdp.commerceCard.promotion.promotions']}}
{{$productOrderCtrl.translations['antibody.pdp.commerceCard.promotion.viewpromo']}}
{{$productOrderCtrl.translations['antibody.pdp.commerceCard.promotion.promocode']}}: {{promo.promoCode}} {{promo.promoTitle}} {{promo.promoDescription}}. {{$productOrderCtrl.translations['antibody.pdp.commerceCard.promotion.learnmore']}}
产品信息
60024-1-IG
种属反应
已发表种属
宿主/亚型
分类
类型
克隆号
抗原
偶联物
形式
浓度
规格
纯化类型
保存液
内含物
保存条件
运输条件
产品详细信息
Immunogen sequence: KISSPTETE RCIESLIAVF QKYAGKDGYN YTLSKTEFLS FMNTELAAFT KNQKDPGVLD RMMKKLDTNS DGQLDFSEFL NLIGGLAMAC HDSFLKAVPS QKRT (3-105 aa encoded by BC001410)
靶标信息
The protein encoded by this gene is a member of the S100 family of proteins containing 2 EF-hand calcium-binding motifs. S100 proteins are localized in the cytoplasm and/or nucleus of a wide range of cells, and involved in the regulation of a number of cellular processes such as cell cycle progression and differentiation. S100 genes include at least 13 members which are located as a cluster on chromosome 1q21. This protein may function in motility, invasion, and tubulin polymerization. Chromosomal rearrangements and altered expression of this gene have been implicated in tumor metastasis.
仅用于科研。不用于诊断过程。未经明确授权不得转售。
生物信息学
蛋白别名: Calgizzarin; epididymis secretory protein Li 43; Metastatic lymph node gene 70 protein; MLN 70; MLN 70, S100 C; Protein S100-A11; Protein S100-C; Protein S100C; S100 calcium-binding protein A11; unnamed protein product
基因别名: HEL-S-43; MLN70; S100A11; S100C
UniProt ID: (Human) P31949
Entrez Gene ID: (Human) 6282